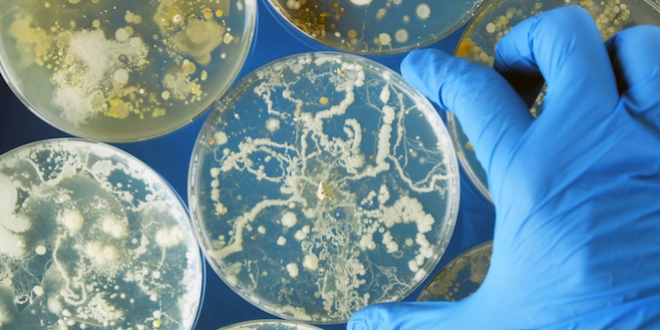

L'ONU s'engage contre les superbactéries
Des dirigeants du monde entier vont se pencher, pour la première fois, sur le problème des superbactéries résistantes aux antibiotiques. Considérée comme une menace sociétale, la résistance bactérienne rend de plus en plus de maladies, comme la tuberculose, extrêmement difficiles à soigner.
Par La rédaction d'Allo Docteurs
Mis à jour le
Les sujets de santé sont rarement abordés à l’Assemblée générale de l’ONU… Pourtant, le 21 septembre, une réunion de haut niveau, rassemblant des chefs de gouvernement, se penchera sur la question des superbactéries, ces organismes qui deviennent résistants à toute forme de traitements antibiotiques.
L'ONU devrait notamment s'engager à renforcer l'encadrement des antibiotiques, à mieux diffuser la connaissance sur ce phénomène, et encourager les traitements alternatifs. Des mesures, dont l'OMS espère qu'elles déclencheront des investissements et des efforts dans tous les pays pour endiguer ce fléau.
700.000 morts par an
"Le problème est connu des professionnels de la santé depuis longtemps et pourtant il ne fait que s'aggraver", explique à l'AFP Keiji Fukuda, représentant spécial du directeur de l'OMS. "Nous sommes en train de perdre notre capacité à traiter les infections. Cela menace aussi notre capacité à produire suffisamment de nourriture", puisque l'agriculture et l'élevage sont aussi très largement touchés.
Une récente étude britannique a estimé que le développement de ces superbactéries hyper-résistantes pourrait être à l'origine de quelque 10 millions de morts par an dans le monde d'ici 2050, soit autant que le nombre annuel de victimes des différentes formes de cancer. Actuellement, on estime que la résistance est responsable de 700.000 morts dans le monde. Les informations manquent cependant dans de nombreux pays pour mesurer précisément le phénomène.
Comment sont-elles devenues résistantes ?
Le danger vient d'une sur-utilisation ou d'un mauvaise utilisation des médicaments antibiotiques, un phénomène observé dans le monde entier. Chez les humains, comme dans l'agriculture et l'élevage, les antibiotiques sont souvent massivement utilisés, non seulement pour soigner les animaux, mais aussi pour favoriser leur croissance. Les bactéries super-résistantes qui se développent ainsi chez les animaux peuvent se propager chez l'homme par la contamination de l'eau ou les déjections.
Bien qu'anticipée dès les années 1950 par le découvreur de la pénicilline Alexander Fleming, la résistance antimicrobienne a atteint des niveaux de plus en plus inquiétants ces dernières années. Cette explosion est notamment facilitée par l'absence de développement d'antibiotiques nouveaux et de recherches.
Une vraie menace sociétale
Les infections rares, comme celle de tous les jours, sont touchées. Parmi les infections les plus difficiles à soigner figurent la tuberculose, les infections contractées à l’hôpital (ndlr : infections nosocomiales) et certaines maladies sexuellement transmissibles.
Les dirigeants du G20 ou de la Banque mondiale se sont aussi récemment alarmés du risque que fait peser la progression des super-bactéries à la croissance mondiale et à la lutte contre la pauvreté. Pour le responsable de l'OMS, la résistance antimicrobienne est devenu plus qu'un problème de santé, "une vraie menace sociétale, comme cela a été le cas avec le changement climatique ou le VIH".










